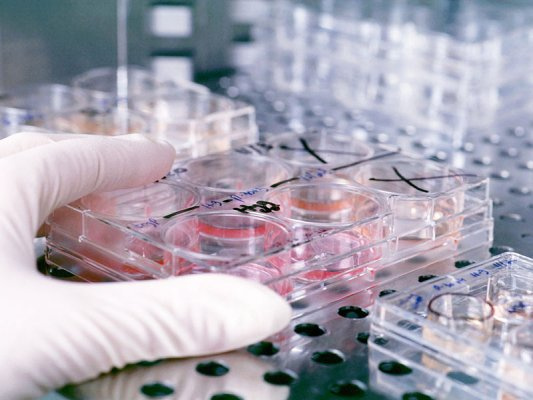

Қўшимча функционаллар
-
Тунги кўриниш
Ўзбекистон янгиликлари
Ўзбекистон янгиликлари

17:20 / 24.11.2015
Ўзбекистонлик милициячи бензини тугаб қолган нафақахўрга ёрдам берди

17:02 / 24.11.2015
Хитой Ўзбекистон орқали ўтадиган тезюрар темир йўл қуради

17:01 / 24.11.2015
Ўзбекистон Афғонистонга Россия инсонпарварлик юкларини ўтказди

15:09 / 24.11.2015
Ўзбекистон Покистонга пахта терадиган комбайнларини сотиб олишни таклиф қилди

12:41 / 24.11.2015
Наманган аэропортининг ўтказиш қобилияти соатига 200 йўловчига етди

11:00 / 24.11.2015
Тошкентда халқаро китоб фестивалининг тақдимоти бўлиб ўтди

08:59 / 24.11.2015
Тошкентда Ўзбекистон ва Корея Республикаси бизнес-форуми бўлиб ўтди
08:52 / 24.11.2015
Ўзбекистонда ОИТСга қарши курашиш тизимининг 25-йиллигига бағишланган анжуман бўлиб ўтади

08:09 / 24.11.2015
БААда ўзбекистонлик аёл ижтимоий тармоқлар орқали беҳаё суратлар тарқатгани учун ҳибс қилинди

21:14 / 23.11.2015
Ўзбекистонда ўтган ҳафтада 183та ёнғин содир бўлди

21:04 / 23.11.2015
"Газпром нефть" Ўзбекистонга нефть етказиб беришни бошлайди

19:44 / 23.11.2015
Андижондаги “Саҳоват” уйи Япония гранти ҳисобига замонавий қурилмалар билан жиҳозланади

19:34 / 23.11.2015
Тошкентда дафн маросимлари хизмати учун тарифлар ва ёдгорликлар ўрнатиш бўйича янги тартиблар жорий этилди

19:12 / 23.11.2015
Ўзбекистоннинг тўртта банки капиталини кўпайтириш учун 275 млрд сўм олади

19:01 / 23.11.2015



